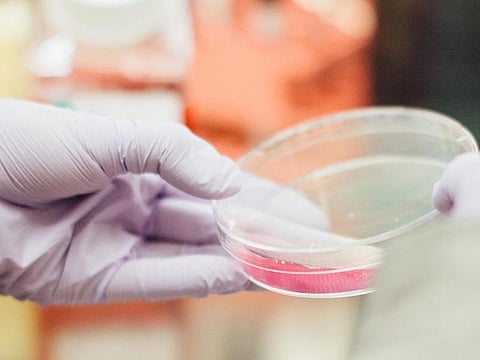

Your immune system is more vulnerable when you're growing a baby, so extra care is a must
Did you know that your immune system is depleted during pregnancy to prevent the body rejecting the growing foetus? This means that extra care is required to prevent exposure to sources of bacteria that may induce food poisoning which can be harmful for both you and your baby. While there's lots of information about what you should avoid eating and coming into contact with when you're expecting, here's a closer look at where danger lies when it comes to bacteria in common foods...
This bacterium may be found in re-heated rice in restaurants as well as rice that has been cooked and left in a warm environment. Ensure all rice you eat is piping hot.
A bacterium that is found in soft cheeses, mould-ripened cheeses, pate, ready-made chilled meals and ready-prepared salads.
It is very rare to develop food poisoning from this bacterium but it may occur if canned food has been damaged.
Found in insufficiently heated food such as chicken, raw and lightly cooked eggs, mayonnaise that has not been refrigerated and some sauces and mousses.
This is transmitted through animal faeces, especially cats, but also through raw meat and soil left on vegetables. Keep cat litters well away from any food preparation, always wear rubber gloves when cleaning the litter tray, avoid any source of raw meat and always wash any fruit and vegetables thoroughly.
Read more: